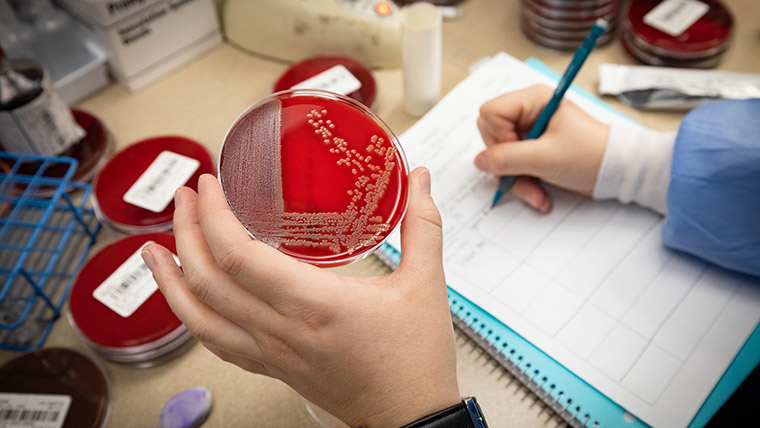

Why major in clinical laboratory sciences at Missouri State?

Enter a high-demand field
When you graduate, you won’t have trouble getting hired. Our graduates have 100% job placement. They work in hospitals, clinics, research centers, forensic labs and many more places.

Get hands-on training
You can preview your career options while in school. During your senior year, you'll have a 12-month clinical rotation at one of four accredited, partner hospitals.
Be ready for certification
Increase your job options and earning power with certification. For seven consecutive years, our students have had a 100% pass rate on the ASCP Board of Certification exam.

Tailor your degree
You can customize this major. Choose an emphasis area (microbiology, molecular diagnostics or management) that matches your goals and interests.
Degree options

Clinical sites and accreditation
In your senior year, you’ll complete a 12-month clinical program at a partner hospital.
The program director at your site supervises you.
- CoxHealth School of Medical Technology – Springfield
- Mercy Hospital School of Medical Lab Science – Joplin
- Mercy Hospital School of Clinical Lab Science – St. Louis
- North Kansas City Hospital
These sites are all accredited by the National Accrediting Agency for Clinical Laboratory Science (NAACLS).
When you finish your clinical program and pass the national registration exam, you’ll become a certified clinical laboratory scientist (also known as a medical laboratory scientist).




